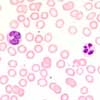

Die Abgrenzung zwischen normal und pathologisch ist zentral bei der Beurteilung von Blutausstrichen und auch für Erfahrene nicht immer leicht. Wichtig ist es hierbei, Artefakte als solche zu erkennen und ihnen keine pathologische Bedeutung beizumessen. Artefakte entstehen durch zu grosse Abstände zwischen Blutentnahme und Verarbeitung (z.B. Autolyse der Neutrophilen), Fehlern beim Ausstreichen (z.B. zerdrückte Zellen) oder bei der Färbung (z.B. Blaustich bei zu basischem pH der Färbelösung, Farbniederschläge). Zu bedenken ist auch immer, dass Normwerte auf der Gauss'schen Normalverteilung beruhen. Das bedeutet, dass am oberen und unteren Ende jeweils 5% der Population ausserhalb des Normbereichs liegen und somit 10% der "Normalen" pathologische Werte aufweisen.